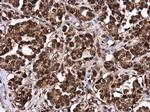
LIN28B Antibody in Immunohistochemistry (Paraffin) (IHC (P))
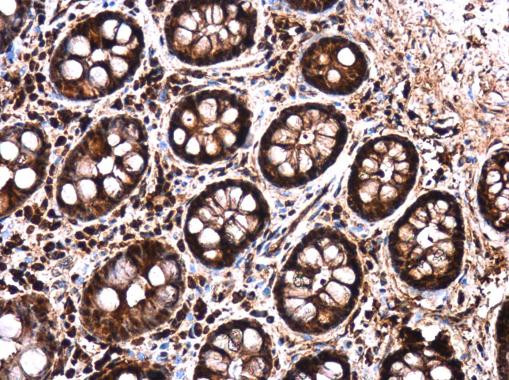
LIN28B Antibody in Immunohistochemistry (Paraffin) (IHC (P))

Search
Invitrogen
LIN28B Polyclonal Antibody
{{$productOrderCtrl.translations['antibody.pdp.commerceCard.promotion.promotions']}}
{{$productOrderCtrl.translations['antibody.pdp.commerceCard.promotion.viewpromo']}}
{{$productOrderCtrl.translations['antibody.pdp.commerceCard.promotion.promocode']}}: {{promo.promoCode}} {{promo.promoTitle}} {{promo.promoDescription}}. {{$productOrderCtrl.translations['antibody.pdp.commerceCard.promotion.learnmore']}}
图: 1 / 3
LIN28B Antibody (PA5-85699) in IHC (P)

Please note: We are reviewing Western blot images included in the antibody testing data in our catalog, including those provided by third parties. Unless expressly labeled or annotated as “raw-unedited”, Western blot images included in the antibody testing data in our catalog may have been edited, optimized or otherwise adjusted for presentation.
产品信息
PA5-85699
种属反应
宿主/亚型
分类
类型
抗原
偶联物
形式
浓度
规格
纯化类型
保存液
内含物
保存条件
运输条件
RRID
产品详细信息
Keep as concentrated solution.
Predicted reactivity: Sheep (82%).
Positive Control: Huh7.
Store product as a concentrated solution. Centrifuge briefly prior to opening the vial.
靶标信息
The GNL1 gene, identified in the human major histocompatibility complex class I region, shows a high degree of similarity with its mouse counterpart. The GNL1 gene is located less than 2 kb centromeric to HLA-E, in the same transcriptional orientation. GNL1 is telomeric to HLA-B and HLA-C.
仅用于科研。不用于诊断过程。未经明确授权不得转售。